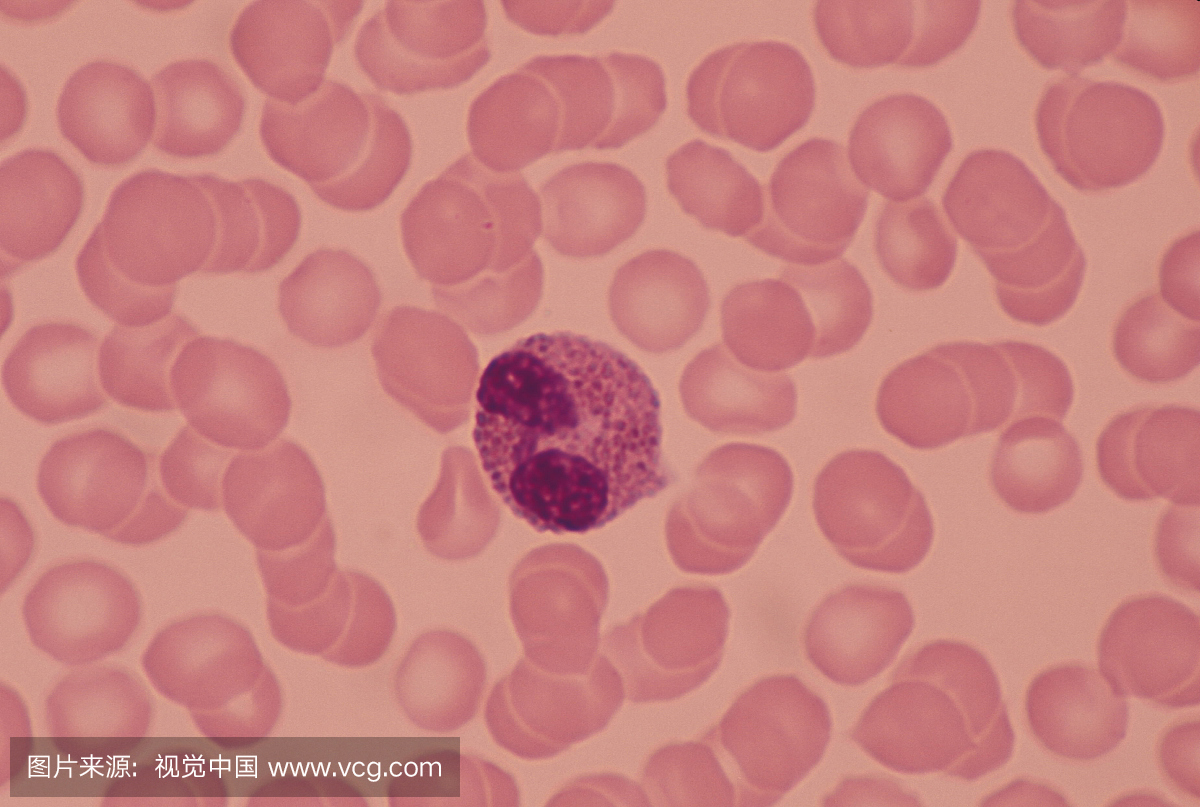
嗜曙红细胞,嗜酸性粒细胞,粒子,细胞核

嗜曙红细胞,嗜酸性粒细胞,细胞质,细胞浆
1200x1200 - 546KB - JPEG

嗜酸性细胞增多症
300x242 - 16KB - JPEG

嗜酸性粒细胞粒细胞
1247x1280 - 537KB - JPEG

嗜曙红细胞,嗜酸性粒细胞,嗜碱细胞,(腺垂体)β
1200x1133 - 502KB - JPEG

嗜酸乳杆菌,嗜酸细胞,水平画幅,人类消化系统
1200x800 - 949KB - JPEG

肾嗜酸细胞瘤
220x220 - 10KB - JPEG
嗜曙红细胞,嗜酸性粒细胞,粒子,细胞核
1200x807 - 512KB - JPEG

嗜酸性粒细胞
800x765 - 67KB - JPEG

嗜曙红细胞,嗜酸性粒细胞,嗜中性粒细胞,中性粒
1200x1181 - 568KB - JPEG

嗜酸粒细胞和嗜酸乳杆菌的区别是什么?_360问
500x338 - 25KB - JPEG

从人类骨髓中成熟的嗜酸性粒细胞的假彩色透射
990x1280 - 700KB - JPEG

嗜酸粒细胞直接计数液 - 商家\/报价\/参数 - 丁香
800x800 - 60KB - JPEG

嗜酸细胞,垂直画幅,温带的花,花
800x1200 - 228KB - JPEG

嗜酸细胞性脑膜炎1例 - 临检 - 中华检验医学网
350x291 - 59KB - JPEG

嗜曙红细胞,嗜酸性粒细胞,嗜碱细胞,嗜碱成分
1200x800 - 429KB - JPEG